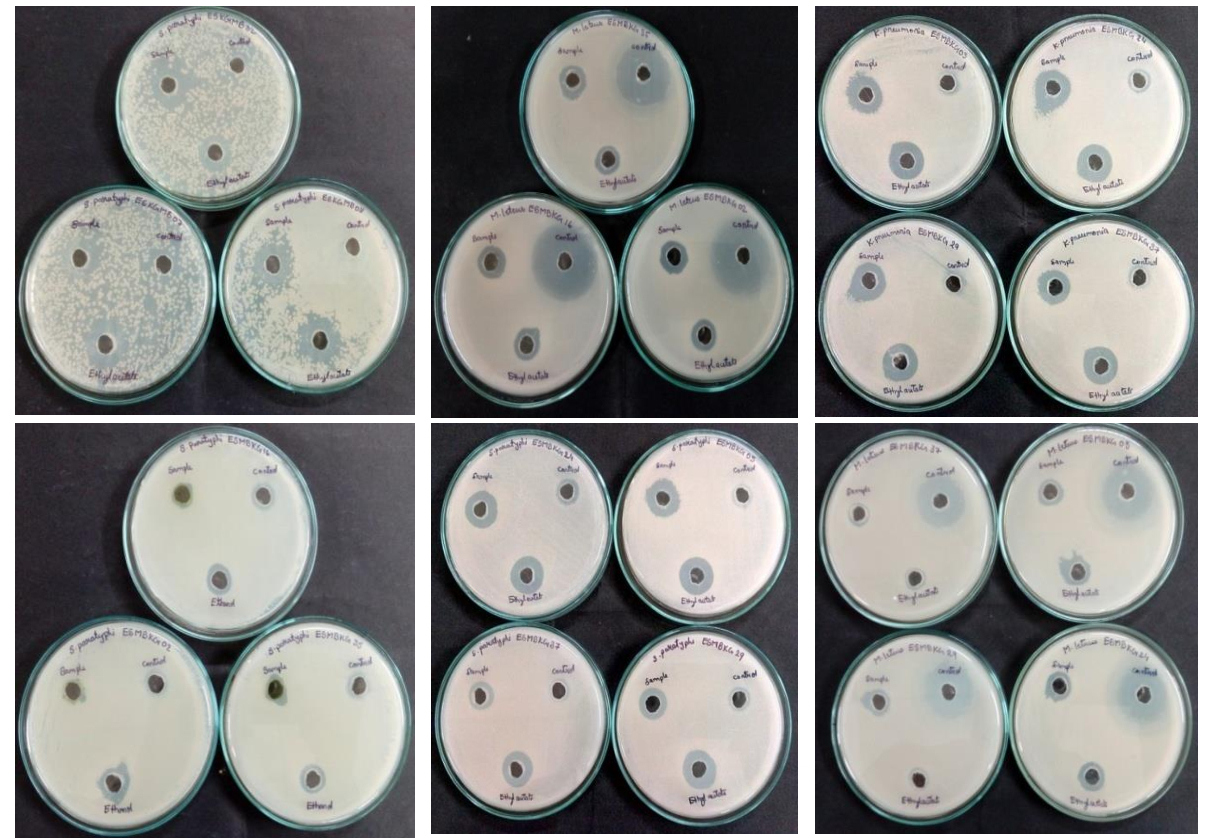

Gunaswetha Kuraganti ¹, Sujatha Edla²*
¹Research Scholar, Department of Microbiology, Kakatiya University, Warangal-506009, Telangana, India
²Assistant Professor, Department of Microbiology, Kakatiya University, Warangal 506009, Telangana, India
*Address for Corresponding Author
Edla Sujatha
Department of Microbiology, Kakatiya University, Warangal 506009, Telangana, India
Abstract
Objective: Focusing on bioproducts, ongoing patterns in drug research have demonstrated that microalgae are promising organisms to outfit novel and more secure naturally vital compounds. Cyanobacteria are considered as potential source of antibiotic production. Materials and Methods: Twenty cyanobacterial strains from different habitats belonging to various genera were isolated cultured and tested for their antimicrobial activity. Among the isolates, percentage of incidence and frequency of Microcystis was more in Badrakali freshwater lake and Adilabad mavala lake. The biomass of cyanobacterial sp were lyophilized and extracted with ethyl acetate and crude extracts were subjected to TLC purification twice and tested for antibacterial activity against two Gram+ve bacteria (Staphylococcus aureus, Micrococcus luteus) and four Gram-ve bacteria (Escherichia coli, Klebsiella pneumonia, Salmonella typhi, Salmonella paratyphi) by Agar well diffusion method. Results: Ten strains showed activity against at least two of the test organisms. Bioactivity was more by extract of ethyl acetate. Extracts of Oscillatoria strains (MBKG02) were shown more antibacterial activity on E. coli (22mm) and S. paratyphi (19mm) where as Microcystis sp (MBKG16, MBKG08) shown more activity against S. paratyphi (20mm). Microcystis (MBKG 07) strain has shown more inhibitory effect on S. paratyphi (10mm). Conclusion: The results obtained in the present study clearly suggest that the production of antibacterial products from cyanobacterial sp could represent a viable and eco-friendly to reduce the use of synthetic drugs. The presence of antibacterial activity was independent of the strain origin.
Keywords: Cyanobacteria, thin layer chromatography, antibacterial activity
Introduction
Since ancient time nature has provided man with broad and diverse amount of pharmacologically active compounds which were isolated and utilized as highly effective drug to combat deadly diseases or manufacture synthetic drugs similar to that found in nature. Till date the antibiotics mostly used are derived from microorganisms of terrestrial soils and aquatic habitats (Bhattacharyya et al., 2013). Pharmaceutical drug discoveries since years depended heavily on the process of empirically screening of large number of pure compounds to provide new leads. Historically, actinomycetes have been the most prolific producers of new bioactive metabolites. But the cyanobacteria (blue green algae) are among the oldest phototropic organisms. Their cultivation without organic substrate can be an economical advantage over the microorganisms (Kaushik and Chauhan, 2008). The search for cyanobacteria with antimicrobial activity has gained importance in recent years due to growing worldwide concern about alarming increase in the rate of infection by antibiotic resistance microorganisms. Biologically active substance was proved to be extracted by cyanobacteria. Different strains of cyanobacteria are known to create intracellular and extracellular metabolites which have a huge fascination as normal well spring of bioactive atoms with an expansive scope of organic exercies such as antibiotics, antiviral, anti tumoural , anti oxidant and anti inflammatory (TÜney İ Cadirci et al., 2006; Cardozo et al., 2007; Patra et al., 2008; Mohammed et al., 2015). The bioactive molecules are produced in an attempt for biological adaptations and tolerance to environmental stress and to confer advantages for their survival (Bhattacharyya et al., 2013).
Algae and cyanobacteria are swiftly proving to be an extremely important source of biologically active secondary metabolites (Gademann and Portmann, 2018). Report on antibiotic activity of cyanobacteria was first reported by (Patterson et al., 1994). More than 150,000 algae are found in all over freshwater on the earth. The screening of extracts from various regular sources is a typical method to find organically unique metabolites. In such research exercise on microalgae like cyanobacteria were observed to be a rich well spring of different product of commercial, pharmaceutical and toxicological premium: primary metabolites, for example proteins, fatty acids, vitamins, pigments and various secondary metabolites with different bioactivities (antifungal, antiviral, antibiotic and other) or cyanotoxins like hepatotoxins and saxitoxins were isolated from cyanobacteria (Volk et al., 2006). Cyanobacteria can be considered as one of the important taxa to be explored for their efficiency (Bhattacharyya et al., 2013). Algae are well springs of amino acids, terpenoids, phlorotannins, steroids, phenolic compounds, halogenated ketones, alkanes and cyclic polysulphides (Taskin et al., 2007).
The aim of study reported here was to isolate the cyanobacteria in Warangal and Adilabad districts of Telangana and study their occurrence in fresh water lakes by calculating their incidence and frequency and to examine the antibacterial activity of various concentrates of cyanobacterial isolates by agar diffusion method. In this investigation we have attempted to assess the antibacterial activity of different organic extracts of cyanobacteria on E. coli, S. aureus, K. pneumonia, M. luteus, S. typhi, S. paratyphi as test organisms.
Materials and methods
Isolation and culturing of cyanobacteria
The cyanobacterial samples were collected from the freshwater lakes and canals of Warangal and Adilabad districts. The samples were collected from pegadapalli lake, stagnant water pool from Reddypalem village, Reddypalem yellamma lake, Badrakali lake, Waddepalli freshwater lake, Adilabad mavala lake at mid winter season in month of August to December by Capillary method. Cyanobacterial strains were isolated and identified by standard microbiological methods (Desikachary. 1959; Rippka et al., 1979). Water samples were inoculated on Blue green agar media (Yadav et al., 2012; El-Aty et al., 2014). Media components in g/lit [NaNO₃ 1.500, K₂HPO₄ 0.0314 , MgSO₄ 0.036 , CaCl₂.2H₂O 0.0367, Na₂CO₃ 0.020, Na₂Mg EDTA 0.001 , citric acid 0.0056 , ferric ammonium citrate 0.006 , final pH after sterilization(at 25°C) 7.1] and Allen Arnon agar media [K₂HPO₄.3H₂O 28.0 g/500ml, MgSO₄ 20g/500ml, CaCl₂.2H₂O 6g/500ml, NaCl 20g/500ml, A&A Fe-EDTA solution 160ml, MnCl2.4H2O 360mg/l, MoO3 85% purity 36.0 mg/l or Na₂MO4.2H₂O 99% purity 61.1mg/l, ZnSO₄.7H₂O 44.0mg/l, CuSO4.5H2O 15.8mg/l, H3BO3 572mg/l, NH₄VO₃ 4.6mg/l, CoCl2.6H₂O 8.0mg/l] by pour plate method and simultaneously cultured in broth of same media. The plates and flasks were incubated for 20days under continuous emission of white cool fluorescent light maintained for 16х 8 L/D cycles with 30μ mol photon m-2s-1 referred as 30°C. The obtained cyanobacterial colonies were sub cultured several times to obtain pure cultures. Identification was done using morphological variation studies and toxonomical approaches according to Desikachary (1959). The percentage of incidence and frequency were calculated by employing the following formula:


Preparation of algal extracts
The axenic cyanobacterial cultures Oscillatoria sp, Microcystis sp, Dictyospaerium sp, Nostoc sp, Chroococcus sp, Anabeana sp were selected and screened for their antimicrobial activity against Staphylococcus aureus, Micrococcus luteus, Escherichia coli, Salmonella typhi, Salmonella paratyphi, Klebsiella pneumonia. For extraction a volume of 3L of 25th day culture was reduced to 200ml by rotary evaporator (SENCO technology Co., Ltd. China) at 40°C. 300ml of ethyl acetate was added and the mixture was shaken for 24hours. The ethyl acetate layer was separated from the aqueous layer. The aqueous layer was shaken again with 300ml of fresh ethyl acetate. The ethyl acetate layers were combined and dried with Na2SO4 in rotary evaporator at 40°C to remove the organic solvent. The remaining residues of ethyl acetate were removed by air dry at 32-38°C. The aqueous layer was discarded. The extracts were weighed and stored at -20°C until use (Bui, 2014).
Chromatographic analysis and purification of cyanobacterial extracts
Thin Layer Chromatography technique can be used to detect compounds by the phenomenon of capillary action, injecting a thin layer adsorbent material into solvent system. The solvents travels due to the different attraction of the analysis to the stationary phase.
The retention factor for each spot can be determined by the equation below:

The analysis of TLC moderately depends on the adsorbent material, temperature and pressure in the solvents as well as the spotting distance. The value of the retention factor is not constant in practice. The dried cyanobacterial ethyl acetate extracts (100mg) were dissolved in 3ml of methanol (25%) for purification using TLC plates (10х10cm; 0.25mm layer thickness). The aliquots were directly spotted two centimeters from the edges of a silica gel coated TLC plate. Separations of crude extracts were done using ethyl acetate: methanol: water (7:2:1) as mobile phase (Bui, 2014). Spots developed on such TLC plates were observed under UV illumination. The illuminated orange spots were eluted separately and dissolved in 3ml methanol (25%), each elute again subjected to TLC purification using Ethyl acetate: methanol: water (7:2:1). Now all spots obtained at second stage were bio assayed for antibacterial activity by agar well diffusion method (Maheep et al., 2014).
Determination of relative percentage of inhibition
The relative percentage of inhibition with respect to positive control was calculated by using the formula:

Where,
a, Inhibition zone of test extract
b, Inhibition zone of the solvent
c, Inhibition zone of the standard drug
Results and discussion
Isolation and culturing of cyanobacteria in different growth media
A total of 20 strains of cyanobacteria belongs to genera Anabeana, Spirulina, Chlorella, Microcystis, Oscillatoria, Nostoc, Chroococcus, Gleocapsa, Nostoc carneum, Lyngbye, Gleotricha, Microchaete, Cylindrospermum, Aphanotheca, phormidium, Dictyospaerium, Merismopedia, Coelospaerium, Rivularia and Tolypothrix were isolated from freshwater lakes of Warangal and Adilabad districts and purified in BG11 and Allen media. Among the isolates, percentage of incidence of Nostoc (43.5) and Gleotrichia (33.3) was more in Waddepalli lake of Warangal, where Spirulina sp and Microcystis sp have shown high P.I (23.7) in Pegadapalli lake and Khanapur lake of Adilabad (27.2) respectively. In all the cyanobacterial genera Gleocapsa sp, Nostoc sp and Microchaete sp shown highest percentage of frequency (66.6) in Reddy pallem pond, stagnant water of Warangal and Khanapur lake of Adilabad. In case of Spirulina highest P.F (80.0) was observed in Waddepalli lake as shown in (table 1). There is no particular correlation between P.I & P.F of isolated strains, because of variability in requirements of cyanobacteria such as vitamins, organic and inorganic constituents from species to species. According to Enevoldsen, (2003) cyanobacteria sp also need different growth conditions like concentration of pH, salinity, temperature, light aeration etc.
Table 1. Percentage of Incidence & frequency of cyanobacterial sp collected from different water sources cultured in BG11 medium
|
Organisms |
Pegada- palli lake |
Reddy- pallum pond |
Wadde- palli lake |
Reddy- pallum lake |
Canal water (Pegadapalli) |
Reddy- pallum village lake |
Badrakali lake |
Adilabad mavala lake |
Adilabad khanapur lake |
Kovali freshwater lake |
||||||||||
|
PI |
PF |
PI |
PF |
PI |
PF |
PI |
PF |
PI |
PF |
PI |
PF |
PI |
PF |
PI |
PF |
PI |
PF |
PI |
PF |
|
|
Anabeana sp |
20.3 |
46.6 |
- |
- |
- |
- |
- |
- |
29 |
60 |
- |
- |
- |
- |
7.3 |
20 |
- |
- |
- |
|
|
Spirullina sp |
23.7 |
53.3 |
- |
- |
23.07 |
33 |
- |
- |
- |
- |
- |
- |
- |
- |
2.94 |
13.3 |
- |
- |
- |
- |
|
Microcystis sp |
16.94 |
20 |
13.6 |
33.3 |
9.3 |
53.3 |
23 |
66.6 |
24.1 |
66.6 |
14.7 |
46.6 |
27.2 |
66.6 |
- |
- |
||||
|
Oscillatoria sp |
15.25 |
20 |
16.6 |
60 |
- |
- |
- |
- |
22.5 |
33.3 |
5.76 |
20 |
24.1 |
66.6 |
- |
- |
- |
- |
- |
- |
|
Nostoc sp |
11.86 |
26 |
- |
- |
43.5 |
80 |
- |
- |
32.2 |
66.6 |
- |
- |
- |
- |
13.2 |
40 |
- |
- |
- |
- |
|
Chroococcus sp |
- |
- |
12.1 |
26 |
- |
- |
11.6 |
33.3 |
- |
- |
19.2 |
33.3 |
- |
- |
- |
- |
- |
- |
12.9 |
33.3 |
|
Gloeocapsa sp |
- |
- |
19.6 |
66.6 |
- |
- |
- |
- |
- |
- |
7.69 |
13.3 |
- |
- |
11.7 |
40 |
6.8 |
13.3 |
- |
|
|
Nostoc carneum |
- |
- |
25.7 |
53.3 |
- |
- |
- |
- |
16.1 |
33.3 |
- |
- |
- |
- |
5.8 |
20 |
- |
- |
- |
- |
|
Lyngbye sp |
- |
- |
12.1 |
33.3 |
- |
- |
- |
- |
- |
- |
- |
- |
- |
- |
- |
- |
- |
- |
- |
- |
|
Gloeotrichia sp |
- |
- |
- |
- |
33.3 |
60 |
- |
- |
- |
- |
- |
- |
- |
- |
- |
- |
- |
- |
9.25 |
26.6 |
|
Microchaete sp |
- |
- |
- |
- |
- |
- |
17.4 |
66.6 |
- |
- |
- |
- |
- |
- |
16.17 |
66.6 |
22.7 |
66.6 |
- |
- |
|
Cylindrospermum sp |
- |
- |
- |
- |
- |
10.4 |
11.9 |
- |
- |
17.3 |
46.6 |
- |
- |
- |
- |
13.6 |
26.6 |
- |
- |
|
|
Aphanotheca sp |
- |
- |
- |
- |
- |
- |
12.7 |
40 |
- |
- |
- |
- |
14.5 |
60 |
8.82 |
40 |
18.1 |
40 |
25.9 |
66.6 |
|
Phormidium sp |
- |
- |
- |
- |
- |
16.2 |
46 |
- |
- |
13.4 |
33.3 |
- |
- |
- |
- |
- |
- |
- |
- |
|
|
Dictyoshaerium sp |
- |
- |
- |
- |
- |
- |
8.1 |
33.3 |
- |
- |
- |
- |
12.9 |
40 |
- |
- |
- |
- |
- |
- |
|
Merismopedia sp |
- |
- |
- |
- |
- |
- |
- |
- |
- |
- |
3.84 |
20 |
- |
- |
19.11 |
66.6 |
- |
- |
9.25 |
20 |
|
Coelosphaerium sp |
- |
- |
- |
- |
- |
- |
- |
- |
- |
- |
- |
- |
- |
- |
- |
- |
- |
- |
20.37 |
60 |
|
Rivularia sp |
- |
- |
- |
- |
- |
- |
- |
- |
- |
- |
- |
- |
- |
- |
- |
- |
- |
- |
16.6 |
53.3 |
|
Tolyprhrix sp |
- |
- |
- |
- |
- |
- |
- |
- |
- |
- |
- |
- |
- |
- |
- |
- |
- |
- |
5055 |
13.3 |
P.I : Percentage of Incidence P.F : Percentage of Frequency
TLC spots and antibacterial activity
All the ten cyanobacterial strains under study showed antibacterial activity against one or other bacteria (Table 2). Ethyl acetate extracts of 10 cyanobacterial strains showed significant antibacterial activity against Gram positive or Gram negative bacteria. Among the isolated strains extracts of Microcytis sp, Oscillatoria sp, Nostoc sp, Anabeana sp, Chroococcus sp, Dictyospaerium sp were shown remarkable antibacterial activity. Microcystis MBKG16, MBKG08, MBKG32, MBKG07 exhibited widespread spectrum of antimicrobial activity against both Gram positive and Gram negative bacterial strains (Table 2). The C band of Microcystis MBKG16 Rf value is 0.84 has shown inhibition zones of 12mm, 8mm, 8mm, 20mm, 10mm on S. aureus. E. coli, K. pneumonia, S. paratyphi, M. luteus respectively. Microcystis MBKG08, MBKG32 have shown remarkable inhibitory effect on S. paratyphi and M. luteus (17mm, 10mm). D and E spots of Dictyospaerium shown good antibacterial activity on E. coli, K. pneumonia, S. paratyphi and M. leteus. The spots E and F of Oscillatoria MBKG02 inhibited the growth of E. coli with maximum inhibitory zone of 22mm, S. paratyphi with 19mm (Figure 1 and 2). Ethyl acetate extracts of Chroococcus sp MBKG24, Anabeana sp MBKG29 showed antibacterial activity against S. aureus. E. coli, K. pneumonia and S. paratyphi. The results showed that broad spectrum antibacterial activity was predominantly observed by all the cyanobacterial strains, due to secondary metabolites secreted by them, which may have various functional groups like carbonyl, nitro methane, alcoholic and phenolic groups (Maheep et al., 2014). Many researchers reported that Nostoc produced bioactive compounds with antibiotic activity against S. aureus, Bacillus cereus (Mian et al., 2003). Skulberg (2000) reported that antibiotics produced by Nostoc sp inhibits the growth of bacteria, notably multidrug resistance S. aureus and biocide resistance P. aeruginosa. Those results are in harmony with the report of our cyanobacterial strains which have biocidal against Gram +ve, Gram –ve pathogenic bacteria. The ability to produce antimicrobial compounds may be significant not only as a defensive mechanism for the cyanobacterial strains but also a good source of the new bioactive compounds from medical point of view. In this work crude ethyl acetate extract of the Dictyospaerium, Microcystis were found to be active when compared with other extracts. Cyanobacteria make collection of bioactive blends including 405 lipopeptides, 5.6% amino acids, 4.2% fatty acids, 4.2% macrolides, 9% amides (Singh et al., 2005). Many of these compounds have been reported to posses antibiotic, pharmacological effects such as antibacterial, antifungal, antiviral, anticancer activities (Mian et al., 2003; Ghazala and Shameel, 2005; Soltani et al., 2005). The use of organic solvents provides more efficiency in extracting compounds which have antimicrobial activity (Cardozo et al., 2007; Mohammed et al., 2015). These cyanobacterial strains exhibit antibacterial activity which makes them significant species for screening of natural products. Therefore it is important to pay more attention to develop antibiotics which could fight against many dreadful diseases.
Figure 1. Zone of Inhibition of cyanobacterial extracts against S. aureus, E. coli, S. typhi, S. paratyphi, M. luteus, K. pneumonia
Figure 1. Zone of Inhibition of cyanobacterial extracts against S. aureus, E. coli, S. typhi, S. paratyphi, M. luteus, K. pneumonia
 Figure 2. TLC developed in solvent system (ethyl acetate: methanol:water (7:2:1 v/v)
Figure 2. TLC developed in solvent system (ethyl acetate: methanol:water (7:2:1 v/v)
MBKG: Microbiology Kuraganti Guna
Table 2. Bioassay of TLC bands against S. aureus, E. coli, K. pneumonia, S. typhi, S. paratyphi, M. leteus with Streptomycin as control. MBKG: Microbiology Kuraganti Guna
|
Cyanobacterial sp |
TLC Bands with Rf values |
Zone of inhibition (mm) against the test organism, streptomycin as control |
||||||
|
S. aureus |
E. coli |
K. pneumonai |
S. typhi |
S. paratyphi |
M. luteus |
Streptomycin |
||
|
Microcystis sp (MBKG16) |
A - 0.47 B - 0.79 C - 0.84 |
-- -- 12 |
-- -- 8 |
-- -- 8 |
-- -- -- |
-- -- 20 |
-- -- 10 |
17 |
|
Microcystis sp (MBKG08) |
A - 0.277 B - 0.6 C - 0.766 |
-- -- 13 |
-- -- 8.2 |
-- -- -- |
-- -- -- |
-- -- 17 |
-- -- 10 |
17 |
|
Microcystis sp (MBKG32) |
A - 0.22 B - 0.458 C - 0.550 D – 0.623 |
-- -- 8 -- |
-- -- 9.4 -- |
-- -- -- -- |
-- -- -- -- |
-- -- 15 -- |
-- -- 11 -- |
17 |
|
Dictyospaerium sp (MBKG35) |
A - 0.27 B - 0.57 C - 0.66 D – 0.81 E – 0.88 |
-- -- -- 10 4 |
-- -- -- 8 -- |
-- -- -- 12 -- |
-- -- -- -- -- |
-- -- -- 20 7 |
-- -- -- 13 2 |
17 |
|
Oscillatoria sp
(MBKG02) |
A - 0.252 B – 0.368 C - 0.578 D – 0.821 E – 0.884 F- 0.968 |
-- -- -- -- 6 -- |
-- -- -- -- 22 16 |
-- -- -- -- -- -- |
-- -- -- -- -- -- |
-- -- -- -- 19 8 |
-- -- -- -- 10 -- |
17 |
|
Nostoc sp
(MBKG07) |
A - 0.27 B - 0.35 C - 0.56 D – 0.06 E – 0.917 |
-- -- -- -- 8 |
-- -- 4 -- 10 |
-- -- -- -- 7 |
-- -- -- -- -- |
-- -- -- -- 8 |
-- -- -- -- 10 |
17 |
|
Microcystis sp (MBKG07) |
A - 0.28 B - 0.44 |
-- 4 |
-- -- |
-- -- |
-- 10 |
-- 16 |
-- 12 |
17 |
|
Oscillatoria sp (MBKG03 |
A - 0.91 B - 0.78 |
-- -- |
6 -- |
10 -- |
-- -- |
14 -- |
10 -- |
17 |
|
Chroococcus sp
(MBKG24) |
A - 0.27 B – 0.59 C - 0.69 D – 0.76 E – 0.78 F- 0.85 |
-- -- -- 8 -- -- |
-- 2 -- 10 -- -- |
-- 6 -- 10 -- -- |
-- -- -- -- -- -- |
-- -- -- 14 -- -- |
-- -- -- 10 -- -- |
17 |
|
Anabeana sp (MBKG29) |
A - 0.32 B – 0.41 C - 0.51 D – 0.65 E – 0.76 F- 0.88 G – 0.97 |
-- -- -- -- -- -- 5 |
-- -- -- -- -- -- 8 |
-- -- -- -- -- -- 12 |
-- -- -- -- -- -- -- |
-- -- -- -- -- -- 16 |
-- -- -- -- -- -- 12 |
17 |
Conclusion
The study reveals that all the cyanobacterial TLC bands of extracted compounds showed considerable antibacterial activity with ethyl acetate extracts of Oscillatoria strains (MBKG02, 03) against E. coli (22mm,16mm,6mm), S. paratyphi (19mm,10mm,8mm). Microcystis strains (MBKG 16,08,32,07) showed activity with zone diameter of 20mm,17mm,15mm,16mm against S. paratyphi whereas 12mm,13mm,8mm,4mm against S. aureus.. The study emphasizes the importance of exploring the bioactive metabolites from cyanobacteria and their antimicrobial activity against pathogenic microorganisms for future biotechnological applications. However whether such extracts will act as effective therapeutic agents remains to be investigated.
Acknowledgements
The authors are thankful to University Grants Commission (UGC-RGNF) for providing financial support to carry out the research work.
Conflicts of interest
There are no conflicts of interest among the authors.
References
Bhattacharyya S, Deep PR, Nayak B, Panigrahi M, Mohapatra B. 2013. Antimicrobial activity of two diazotropic cyanobacteria against Staphylococcus aureus. International Journal of Mededicinal and Aromatic Plants, 3:283-292.
Bui TH. 2014. Cyanobacteria as source of new antifungals Dissertation, University of Greifswald, Germany.
Cardozo KH, Guaratini T, Barros MP, Falcão VR, Tonon AP, Lopes NP, Campos S, Torres MA, Souza AO, Colepicolo P, Pinto E. 2007. Metabolites from algae with economical impact. Comparative Biochemistry and Physiology Part C: Toxicology and Pharmacology, 146(1):60-78.
Desikachary TV. Cyanophyta. 1959. New Delhi. Indian Council of Agricultural Research, p 686.
El-Aty AM, Mohamed AA, Samhan FA. 2014. In vitro antioxidant and antibacterial activities of two fresh water Cyanobacterial species, Oscillatoria agardhii and Anabaena sphaerica. Journal of Applied Pharmaceutical Science, 4(7):069-075.
Enevoldsen HO. 2003. Manual on harmful marine microalgae Hallegraeff GM, Anderson DM, Cembella AD, (eds), Unesco.
Gademann K, Portmann C. 2008. Secondary metabolites from cyanobacteria: complex structures and powerful bioactivities. Current Organic Chemistry, 12(4):326-41.
Ghazala B, Shameel M. 2005. Phytochemistry and bioactivity of some freshwater green algae from Pakistan. Pharmaceutical Biology, 43(4):358-369.
Kaushik P, Chauhan A. 2008. In vitro antibacterial activity of laboratory grown culture of Spirulina platensis. Indian Journal of Microbiology, 48(3):348-352.
Maheep K, Alok KR, Kumar RA. 2014. Use of TLC, UV, NMR, IR and LC-Ms/ MS for purification and identification of Antibacterial compounds. World Journal of Pharmacy and Pharmaceutical Sciences, 3:1075-1085.
Mian P Heilmann J, Bürgi HR, Sticher O. 2003. Biological screening of terrestrial and freshwater cyanobacteria for antimicrobial activity, brine shrimp lethality, and cytotoxicity. Pharmaceutical Biology, 41(4):243-247.
Mohammed MHC, Khadizatul K, Mohammad BH, Golam MM, Tahsina J, Karim MR, Mehedy ME. 2015. Screening of Antibacterial and Antifungal Activity of Freshwater and Marine Algae as a Prominent Natural Antibiotic Available in Bangladesh. International Journal of Pharmacology, 11(7):828-833.
Patra JK, Rath SK, Jena K, Rathod VK, Thatoi H. 2008. Evaluation of antioxidant and antimicrobial activity of seaweed (Sargassum sp.) extract: A study on inhibition of Glutathione-S-Transferase activity. Turkish Journal of Biology, 32(2):119-125.
Patterson GML, Larsen LK, Moore RE. 1994. Bioactive natural products from blue green algae. Journal of Applied Phycology, 6:151-157.
Rippka R, Deruelles J, Waterbury JB, Herdman M, Stanier RY. 1979. Generic assignments, strain histories and properties of pure cultures of cyanobacteria. Jornal of General Microbiology, 111(1):1-61.
Singh S, Kate BN, Banerjee UC. 2005. Bioactive compounds from cyanobacteria and microalgae: an overview. Critical Reveiws in Biotechnology, 25(3):73-95.
Skulberg OM. 2000. Microalgae as a source of bioactive molecules–experience from cyanophyte research. Journal of Applied Phycology, 12(3):341-348.
Soltani N, Khavari-Nejad RA, Tabatabaei Yazdi M, Shokravi S, Fernandez-Valiente E. 2005. Screening of soil cyanobacteria for antifungal and antibacterial activity. Pharmaceutical Biology, 43(5):455-459.
Taskin E, Ozturk M, Kurt O. 2007. Antibacterial activities of some marine algae from the Aegean Sea (Turkey). African Journal of Biotechnology, 6(24):27-46.
TÜney İ, Cadirci BH, Ünal D, Sukatar A. 2006. Antimicrobial activities of the extracts of marine algae from the coast of Urla (Izmir, Turkey). Turkish Journal of Biology, 30(3):171-175.
Volk RB, Furkert FH. 2006. Antialgal, antibacterial and antifungal activity of two metabolites produced and excreted by cyanobacteria during growth. Microbiology Research 161(2):180-186.
Yadav SH, Sinha RP, Tyagi MB. 2012. Antimicrobial activity of some cyanobacteria. International Journal of Pharmacy and Pharmaceutical Sciences, 4(3):631-5.